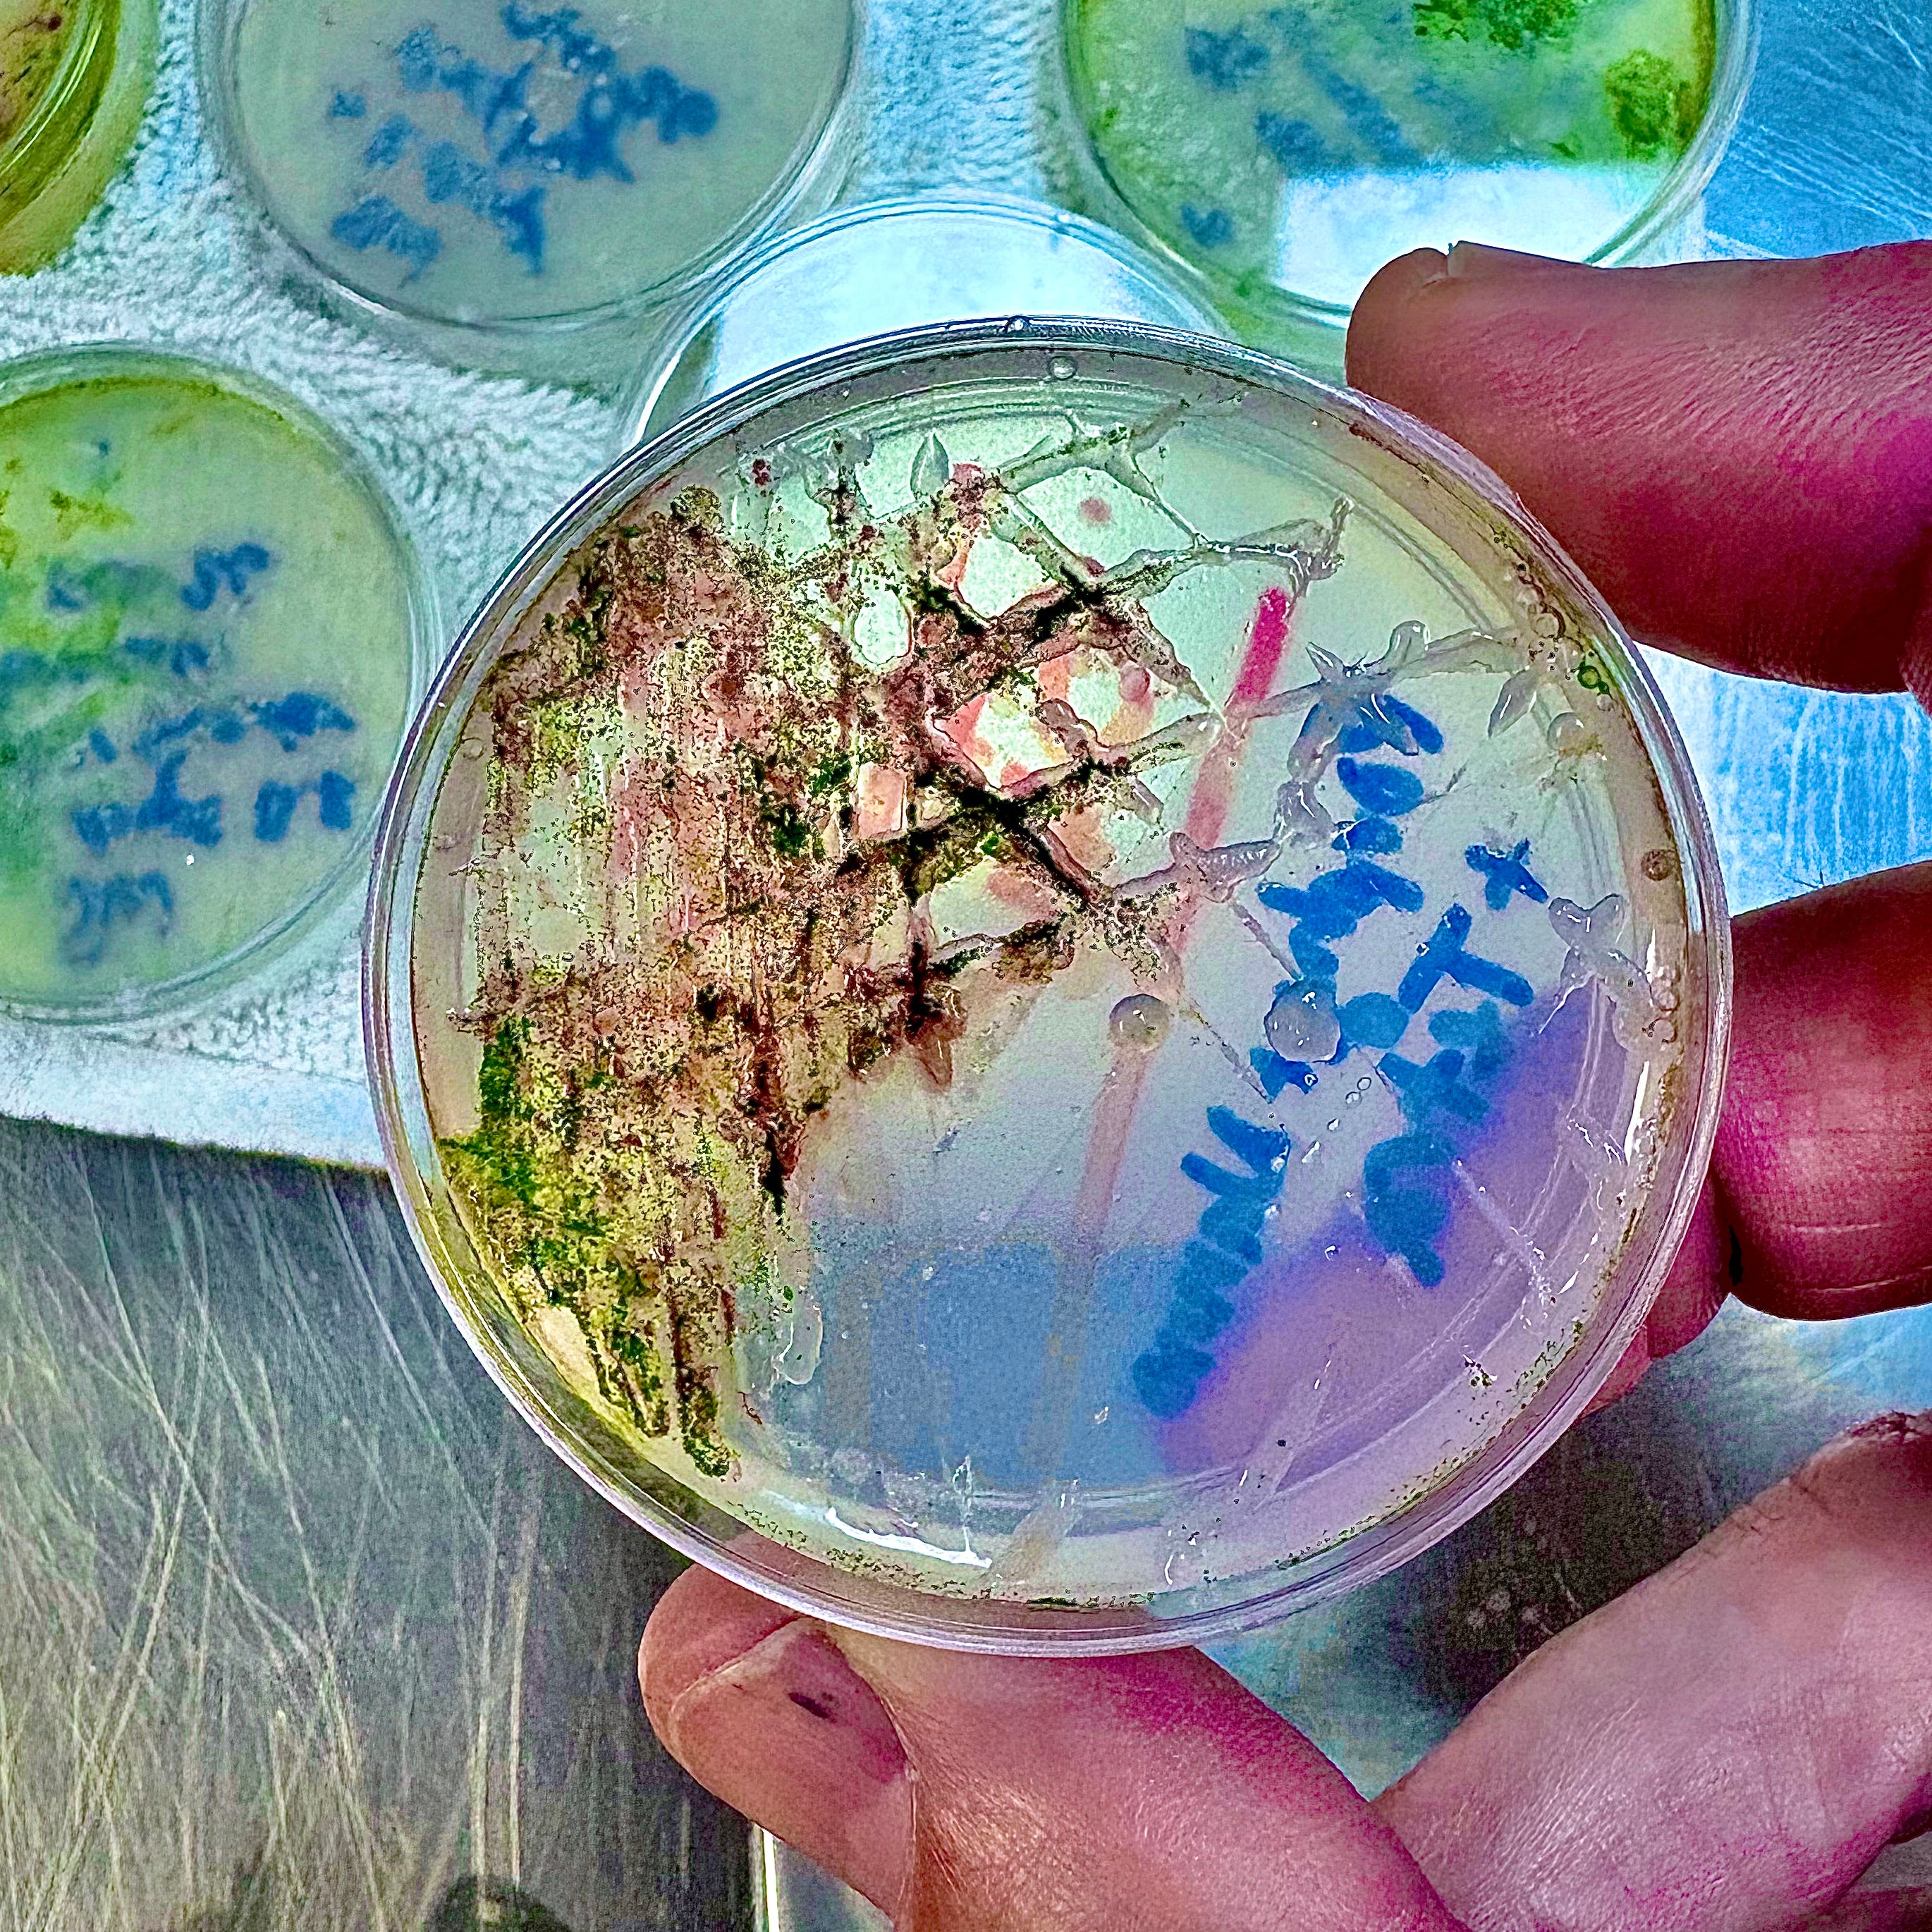
Mixed Marine Microbiology Isolation Kit

The Mixed Marine Microalgae Isolation Kit is designed to support the isolation and cultivation of diverse marine microalgae from environmental samples. Using solid agar media, this kit enables users to separate mixed populations into individual colonies for observation, experimentation, or further culturing. It is well suited for classroom, research, and exploratory applications where understanding microalgal diversity and growth is the goal.
Kit contains:
- Microalgae incubator container with 5 volt LED mat
- Kit instructions sheet
- 20 60mm agar plates
- 500mL plastic bottle containing approximately 400mL of seawater agar
-
Bag 1:
- 50mL monocultures of 5 unique marine algae strains: Tetraselmis, Nannochloropsis, Isochrysis, Chaetoceros, Porphyridium
- 15mL sample tubes to create subsamples of each culture, mixed marine cultures, and to perform serial dilutions (x20 tubes, enough for 5 groups)
- 1mL sterile plastic transfer pipettes (x5)
- Baggie of seawater salts to make 500mL of seawater media (x1)
- 2mL tube of F/2 nutrients (x1)
- 50mL monocultures of 5 unique marine algae strains: Tetraselmis, Nannochloropsis, Isochrysis, Chaetoceros, Porphyridium
-
Bag 2:
- 2mL tube of F/2 nutrients to add to agar after reheating (x1)
- 1mL sterile plastic transfer pipettes (x5)
- Individually wrapped toothpicks (x20)
- 12” x 4” sheet of Parafilm to seal plates (x1)
- 2mL tube of F/2 nutrients to add to agar after reheating (x1)
-
Bag 3:
- 50mL centrifuge tubes to isolate and scale up algae cultures from agar plates (x5)
- Individually wrapped toothpicks (x5)
- Beaker bags (x5)
- Secchi sticks (x5)
- Baggie of seawater salts to make 500mL of seawater media (x6)
- 2mL tube of F/2 nutrients (x6)
- 50mL centrifuge tubes to isolate and scale up algae cultures from agar plates (x5)
Mixed Marine Microbiology Isolation Kit
$ 82.75
Pairs well with

Mixed Marine Microbiology Isolation Kit
$ 82.75


